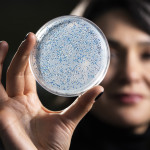

Tag Bacteriology
Resurrected ancient enzyme offers new window into early Earth and the search for life beyond it
UW researchers are helping us understand the origins of life on Earth and possibly recognize signs of life elsewhere.
Viruses found in carbon-storing wetlands play an active role in shaping ecosystem health
The viruses could also help determine if a wetland has been damaged or if restoration efforts are working.
Project to explore enzyme behind early evolution of life on Earth
A team of scientists at UW–Madison led by bacteriology professor Betül Kaçar will explore the paleoenvironments and ancient history of Earth by bridging paleontology, artificial intelligence, synthetic biology and evolution.
New recipes for origin of life may point way to distant, inhabited planets
A team led by scientists at UW–Madison has exploited those limitations of chemical combinations to write a cookbook with hundreds of recipes that have the potential to give rise to life.
Earlier algae blooms, lingering toxins: Invasive species cause big changes to a lake’s microbial community
Two invasive species are having an outsized impact on toxic algae blooms according to a recent study from UW–Madison, which shows that algal toxins stay in water longer thanks to the combined effects of invasive species on Lake Mendota's microbial community.
The search for how life on Earth transformed from simple to complex
A new NASA collaboration of astrobiology researchers co-led by a UW–Madison professor will spend the next five years dedicating their efforts to understanding how life evolved on earth, and how it possibly could evolve on other worlds.
Donohue to lead Wisconsin Energy Institute
Tim Donohue, a professor of bacteriology, has led the institute as interim director since 2017. WEI provides leadership in energy and clean technology research, scholarship, education and outreach.
UW alum masterminding next generation data storage: A solution to the datapocalypse?
In a meeting at the Weinert Center for Entrepreneurship at the Wisconsin School of Business, Hyunjun Park said the device will hold digital information in DNA – life’s evolution-perfected “data storage” molecule.
Radiation-resistant E. coli evolved in the lab give view into DNA repair
Scientists in the University of Wisconsin–Madison Department of Biochemistry are blasting E. coli bacteria with ionizing radiation once a week to watch evolution happen in real time as the bacteria become radiation resistant.
Gene-editing tool now being used to develop better antibiotics
Jason Peters and colleagues have repurposed the gene-editing tool CRISPR to study which genes are targeted by particular antibiotics, providing clues on how to improve existing antibiotics or develop new ones.
‘Foray’ draws scientists to Wisconsin in search of mushrooms, fellowship
Now in its 44th year, the Smith Lake States Mycological Foray gathers mushroom experts to collect samples, share mycological gossip and debate the evolution of these enigmatic organisms.
Set in amber, fossil ants help reconstruct evolution of fungus farming
New UW–Madison research makes it clear that the constant threat of crop parasites repeatedly pushed evolution in ants in strikingly similar directions, creating structures that helped the ants reinforce their partnership with bacteria.
An ocean apart, carnivorous pitcher plants create similar communities
Asian pitchers transplanted to Massachusetts bogs can mimic the living communities of natives so well that the pitcher plant mosquito — a specialized insect that evolved to complete its life cycle exclusively in North American pitchers — lays eggs in the impostors, new research shows.
Corn that acquires its own nitrogen identified, reducing need for fertilizer
The corn secretes copious globs of mucus-like gel harboring bacteria that convert atmospheric nitrogen into a usable form, answering a longtime quest of scientists.
Searching the sea, and bacterial battles, for new antibiotics
Researchers in pharmacy and bacteriology say their discovery would not have been possible without a cross-college collaboration going back nearly a decade.
UW wins $7 million grant to wean crops from nitrogen fertilizers
Researchers from the University of Wisconsin–Madison and the University of Florida will use a $7 million grant from the U.S. Department of Energy to study how some plants partner with bacteria to create usable nitrogen and to transfer this ability to the bioenergy crop poplar.